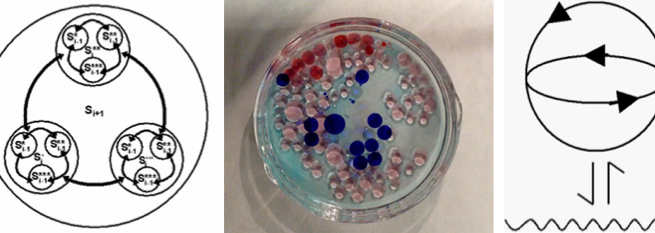

Projects Realised
This is the archive of Summer Session Projects realised since 2009.
In Offering (2024)
Nanno Simonis
Sponsor: V2_ , Host: CairoTronica
Staring at People Staring at Phones (2024)
Daniël Korssen
Sponsor: V2_ , Host: Sardegna Teatro
Chemtrail Aeromancy [Ch-A] (2024)
Djatá Bart-Plange
Sponsor: V2_ , Host: Sardegna Teatro
LILLU (2023)
Sophie Mars and Quintus Glerum
Sponsor: V2_Lab Host: Cairotronica
DANCE OF THE BROKEN (2023) – رقصة المنكسر
Ali Talaat
Sponsor: Cairotronica, Host: V2_Lab
Meditations from the Symbiocene (2022)
Miche O'Higgins
Sponsor: Goethe-Institut Host: V2_Lab
OBJECT ORIENTED CHOREOGRAPHY (2022)
Francesco Luzzana
Sponsor: Sardegno Teatro Host: V2_Lab
FLYLYF (2021)
Marta Romanelli, Ludovica Lotito
Sponsor: V2_Lab Host: V2_Lab
Portrait of Meta-citizens (2021)
Veeeky
Sponsor: National Taiwan Museum of Fine Arts Host: V2_Lab
Dammi sa manu, chi so gherrende (2021)
Sara Persico
Sponsor: Sardegna Teatro Host: V2_Lab
Forced Mechanics’ (2020)
Oihane Iraguen, Jonathan García Lana ‘Tunipanea’
Sponsor: Tabakalera, Host: Tabakalera
Interference 53°N,42°E – v2.0 (2020)
andipath Nath and Nikzad Arabshahi
Sponsor: V2_Lab, Host: V2_Lab
Flickering Silk Thread (2020)
Long Pan
Sponsor: Points Center for Contemporary Art, Host: Points Center for Contemporary Art
You Can’t Automate Me (2020)
Katarina Jazbec & Angeliki Diakrousi
Sponsor: V2_Lab, Host: V2_Lab
Grasp, Kneel, Hold, Count, Pray (2020)
Li Tingwei
Sponsor: Points Center for Contemporary Art, Host: Points Center for Contemporary Art
NONEYE (2019)
Kuo Chih-Yi
Sponsor: National Taiwan Museum of Fine Arts, Host: V2_Lab
A Ghostly Life (2019)
Minke Nouwens Sponsor: V2_Lab, Host: Points Center for Contemporary Art
Esper (2019)
Jasper van Loenen
Sponsor: V2_Lab, Host: Art Center Nabi
Stars In Formation (2019)
Tengchao Zhou
Sponsor: Points Center for Contemporary Art, Host: V2_Lab
Schrödinger’s Baby (2019)
Tzusoo
Sponsor: Art Center Nabi, Host: V2_Lab
Aesthetics of Exclusion (2018)
Sjoerd ter Borg
Sponsor: V2_Lab, Host: Art Center Nabi
Time Shift (2017)
Mark IJzerman
Sponsor: V2_Lab, Host: Art Center Nabi
Ex Topia (2017)
PLATEAURESIDUE, Aljaž Celarc & Eva Pavlic Seifer
Sponsor: MoTA, Host: V2_Lab
This Time Is Not The Place (2017)
Ryan Cherewaty
Sponsor: V2_Lab, Host: Arquivo 237
The Machine in the Middle (2017)
Claudia Oliveira
Sponsor: Arquivo 237, Host: V2_Lab
The Flag of Data (2017)
Yeoul Son
Sponsor: Art Center Nabi, Host: V2_Lab
Near Strangers (2017)
DIASPORA, Constanza Casamadrid & Juan León
Sponsor: UNTREF, Host: V2_Lab
Ways of moving: Tango (2016)
Joana Chicau
Sponsor: V2_Lab, Host: Untref/Espacio Nixso
Web Spaces (2016)
Jip de Beer
Sponsor: V2_Lab, Host: Kitchen Budapest
Audio-Visual Map (2016)
Gábor Pribék
Sponsor: Kitchen Budapest, Host: Chronus Art Center
Emotion Hero (2016)
Ruben van der Ven
Sponsor: V2_Lab Host: Arquivo 237
0 – 255 (2016)
Susana Sanches
Sponsor: Arquivo 237, Host: V2_Lab
Origin: Cycle #1 (2016)
Mischa Daams
Sponsor: V2_Lab, Host: Art Center Nabi
Pickcoin (2016)
Inari Wishiki
Sponsor: Interactive Media Design Lab, NAIST, Host: V2_Lab
Extraneous Relationship (2016)
Jun Hyoung San
Sponsor: Art Center Nabi, Host: V2_Lab
Analog Sun Tracking (2013)
Johannes Langkamp
Sponsor: V2_Lab, Host: Chronus Art Center
II (2009)
Weiyi Hu
Sponsor: Chronus Art Center, Host: V2_Lab